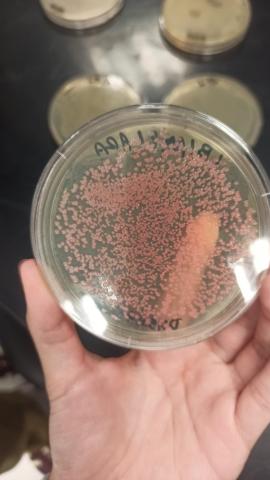
Cultura de bactérias transformadas

Semana Acadêmica da Biologia

Durante toda esta semana, o curso de Biologia da Universidade Mackenzie realizou uma série de eventos, fomentando o ensino de ciências e o desenvolvimento profissional dos estudantes de graduação. Este conjunto de eventos também envolveu a ABE Brasil, e aproveitamos a oportunidade para receber duas escolas em nosso campus.
Na segunda-feira, recebemos 65 alunos do 10º ao 12º ano da Escola Ordânia Janone Crespo, localizada na cidade vizinha de Santo André. E na quarta, quinta e sexta-feira, recebemos 30 alunos do 11º ano, que estão cursando o curso de Técnico em Farmácia na Escola Paulo Egydio. Estes alunos concluíram a Série Abreviada de Fundamentos de Biotecnologia conosco, enquanto os primeiros realizaram a atividade de Introdução à Biotecnologia.
No geral, foi uma semana agitada para as escolas e para nossa equipe, e estamos felizes por termos contribuído para a formação desses alunos.

